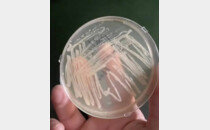

‘부자아빠’ 기요사키, 비트코인 폭락에도 한마디 “난 안 판다”

황수영 기자ghkdtndud119@donga.com2025-11-17 14:11:00

로버트 기요사키 모습. 『부자아빠 가난한 아빠』의 저자인 그는 비트코인 하락장에도 추가 매수 의지를 밝히며 낙관론을 드러냈다. 사진=뉴시스
● “나는 팔지 않는다”… 비트코인 폭락 원인은 ‘현금 부족’
기요사키는 15일(현지 시간) 자신의 SNS에 글을 올려 최근 비트코인 가격 급락에 대한 입장을 밝혔다. 그는 “비트코인이 떨어지고 있지만 나는 팔지 않고 기다리고 있다”며 “모든 시장이 흔들리는 이유는 전 세계가 현금 부족(cash shortage)에 빠져 있기 때문”이라고 진단했다.
● 대규모 통화 발행 예고… “폭락이 끝나면 더 살 것”
그러면서 미국 헤지펀드 EMA 창립자 로렌스 리파드(Lawrence Lepard)의 ‘빅 프린트(Big Print)’ 개념을 언급하며 “세계는 막대한 부채에 빠져 있어 결국 대규모 통화 발행이 시작될 것”이라고 전망했다. 그는 “그 과정에서 금·은·비트코인·이더리움은 가치가 높아지고, 법정통화(fiat money)는 가치가 하락할 것”이라고 덧붙였다.
기요사키는 비트코인의 한정된 공급량도 강조했다. 그는 “비트코인은 2100만 개만 존재한다”며 “이번 폭락이 끝나면 더 매수할 것”이라고 밝혔다.
앞서 그는 지난 4월에도 비트코인 가격이 장기적으로 100만 달러에 도달할 것이라고 주장한 바 있다. 당시에도 “단기 조정은 불가피하지만, 하락 시 추가 매수할 계획”이라고 밝히며 강한 상승론을 펼쳤다.

서울 강남구 서초구 빗썸라운지 강남본점에서 비트코인 모형이 놓인 바닥에 코인 시세 그래프가 비치는 모습. 2025.7.23/뉴스1
매체는 기요사키의 발언이 때때로 공포 심리를 자극해 시장 변동성을 키울 수 있다는 분석을 소개했다. 이 때문에 업계에서는 “기요사키의 전망은 시장 흐름을 참고하는 수준에서 활용해야 할 뿐, 직접적인 투자 조언으로 받아들이기에는 위험하다”는 지적이 나온다.
전문가들은 그의 가격 전망이 과거에도 여러 차례 과장됐던 만큼, 그의 발언을 개별 투자 조언이 아니라 글로벌 경제 흐름을 해석하는 ‘거시적 서사(macro storytelling)’ 차원에서 이해해야 한다고 강조했다.
황수영 기자 ghkdtndud119@donga.com